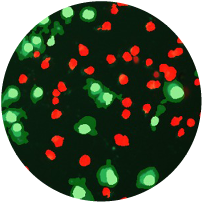

| 全新一代ImageXpress Pico 自动细胞成像系统惊艳亮相 |

集图像自动获取和智能分析于一身的桌面式成像系统
|
它能为您做什么?
|
想对它深入了解么? |
|
 |
|
| 浏览网页 观看产品视频了解更多 |
下载应用资料
细胞凋亡检测等应用 |
下载产品介绍 查看它的性能优势 |
|
| 新一代自动细胞成像系统ImageXpress Pico | 不能正确显示?请点击此处浏览 |


|
|
||
邮件偏好 | 隐私政策 | 服务条款 | 商标标识 | 订阅 仅用于科研。不用于诊断过程。此处提及的各项商标所有权归 Molecular Devices, LLC 或其各自所有权人所有。©2017 Molecular Devices, LLC |